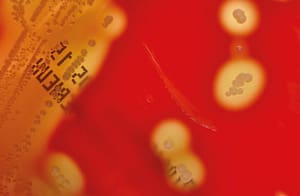
Detección de la colonización asintomática en orofaringe por Streptococcus pyogenes mediante dos métodos diagnósticos

Detección de la colonización asintomática en orofaringe por Streptococcus pyogenes mediante dos métodos diagnósticos
La infección por Streptococcus pyogenes, también conocida como Streptococcus β-hemolítico del grupo A, puede ocasionar enfermedades supurativas (pyogenes: productor de pus) en el ser humano. Entre estas enfermedades se encuentran la faringoamigdalitis, la fascitis necrotizante, entre otras, que suelen presentarse de forma aguda y que con frecuencia evolucionan hacia procesos complicados.
Gabriela Vasco1 *, Consuelo Luna1
1 Universidad Central del Ecuador – Facultad de Ciencias Médicas – Laboratorio de Microbiología – Quito – Ecuador
Revista de la Facultad de Medicina
Print version ISSN 0120-0011
rev.fac.med. vol.65 no.4 Bogotá Oct./Dec. 2017
http://dx.doi.org/10.15446/revfacmed.v65n4.59741
* Correspondencia: Gabriela Vasco.
Laboratorio de Microbiología, Facultad de Ciencias Médicas, Universidad Central del Ecuador. Iquique N14-121 y Sodiro -Itchimbía, Sector El
Dorado, oficina: Suite Edificio de Laboratorios. Teléfono: +593 2 2223725, ext.: 158. Quito. Ecuador.
Correo electrónico: gpvasco@uce.edu.ec
Ciudad Universitaria Carrera 30 No. 45-03, Bogotá, D.C.
revista_fmbog@unal.edu.co
Resumen
Introducción: La Streptococcus pyogenes causa infecciones supurativas en la piel, en las mucosas y de carácter sistémico. Su detección oportuna es importante para evitar el desarrollo de complicaciones no supurativas. Además, el estado de portador puede ser una fuente potencial de autoinoculación o de brotes infecciosos.
Objetivo: Determinar la presencia de estudiantes de medicina en estado de portador de S. pyogenes mediante dos métodos diagnósticos.
Materiales y métodos: Se realizó un estudio de corte transversal con muestreo por conveniencia donde se analizaron muestras de orofaringe por inmunoensayo enzimático StrepA y cultivo bacteriano en agar base sangre de cordero al 5% más pruebas diferenciales con el objetivo de detectar la presencia de S. pyogenes.
Resultados: De 77 muestras incluidas en el análisis, 3 (3.9%) fueron positivas por el cultivo microbiológico para S. pyogenes y ninguna por el método StrepA.
Conclusión: El hallazgo de la bacteria S. pyogenes entre los estudiantes de medicina asintomáticos alerta de un potencial infeccioso. En la comparación de los métodos diagnósticos para su detección, los hallazgos validan el uso del cultivo sobre el del StrepA, en el caso de que se desee estimar la presencia de portadores de dicho agente.
Palabras-clave: Streptococcus pyogenes, Faringitis, Medios de cultivo, DeCS,
Abstract
Introduction: Streptococcus pyogenes causes suppurative skin, mucosal and systemic infections. Timely detection is important to avoid the development of nonsuppurative complications. In addition, carrier status can be a potential source of autoinoculation or infectious outbreaks.
Objective: To establish the status as S. pyogenes carriers of medical students using two diagnostic methods.
Materials and methods: A cross-sectional study was carried out with convenience sampling, in which samples from the oropharynx were analyzed by enzyme Strep-A immunoassay and bacterial culture on sheep blood agar at 5%, plus differential tests to detect the presence of S. pyogenes.
Results: Out of 77 samples included in the analysis, 3 (3.9%) were positive for the microbiological culture for S. pyogenes and none for the Strep-A method.
Conclusion: Finding the bacterium S. pyogenes among asymptomatic medical students is a warning sign of a potential infection. The comparison of the diagnostic methods for detection showed that the findings validate the use of the culture over Strep-A, if estimating the presence of carriers of said agent is desired.
Key words: Streptococcus pyogenes; Pharyngitis; Culture Media (MeSH)
Introducción
La infección por Streptococcus pyogenes, también conocida como Streptococcus β-hemolítico del grupo A, puede ocasionar enfermedades supurativas (pyogenes: productor de pus) en el ser humano. Entre estas enfermedades se encuentran la faringoamigdalitis, la fascitis necrotizante, entre otras, que suelen presentarse de forma aguda y que con frecuencia evolucionan hacia procesos complicados.
La incidencia de la enfermedad estreptocócica suele relacionarse con ciertos factores de riesgo. Los adultos mayores y los niños suelen ser los más afectados por la infección faríngea, donde la S. pyogenes ocasiona el 15-37% de las infecciones en niños y el 5-20% de las infecciones en adultos 1. Otros factores de riesgo relacionados son la vacunación reciente contra la varicela o estar en el periodo de convalecencia de esta enfermedad, donde el riesgo para enfermar se eleva hasta 40 veces 2.
Dado que la infección por S. pyogenes tiene un papel importante en la patogenia de trastornos autoinmunes como la fiebre reumática y la glomerulonefritis post-infecciosa, su detección y eliminación durante la fase aguda del proceso infeccioso se lleva a cabo con precisión para evitar el uso irracional de antibióticos y con rapidez para evitar la progresión de la respuesta inmunológica; la eliminación solo es alcanzada con el tratamiento antibiótico, inclusive en la faringoamigdalitis, que podría ser una infección autolimitada 3.
Los métodos empleados para la detección de S. pyogenes incluyen el cultivo bacteriano tradicional (prueba o patrón de oro) y la detección antigénica 4. Ambos métodos son sensibles, específicos y económicos cuando se aplican al estudio en sujetos enfermos y en estudios in vitro5,6. Su diferencia radica en que la detección antigénica es más rápida que la detección por cultivo y en que la primera se puede realizar en el consultorio médico, mejorando el tiempo de respuesta para la instauración del tratamiento; sin embargo, se recomienda que sus resultados negativos se confirmen con el cultivo.
Del mismo modo, la infección faríngea puede transcurrir con periodos de colonización asintomáticos cuya frecuencia puede llegar a ser de 15-33% 7,8. Los factores de riesgo asociados con el estado de portador pueden ser la hipertrofia adenofaríngea 9, ser niño, portar los tipos emm 1, 3, 12 y 28 10 y ser trabajador de la salud 11. Las consecuencias de ser portador asintomático no están del todo claras, pero los sujetos pueden ser fuentes potenciales de brotes infecciosos o de autoinoculación en heridas de la piel 10. Es por ello que la determinación del estado de portador puede resultar importante en los contextos donde persistan dichos factores de riesgo; sin embargo, no se ha determinado si esta situación puede ser detectada con facilidad por los métodos diagnósticos tradicionales.
En este estudio se aplicaron dos pruebas diagnósticas usadas para detectar S. pyogenes en muestras faríngeas de estudiantes de tercer semestre de la carrera de Medicina de la Facultad de Ciencias Médicas de la Universidad Central del Ecuador; las pruebas se realizaron con el fin de dilucidar el porcentaje de portadores y de determinar cuál método podría ser más sensible para diagnosticar la colonización asintomática.
Materiales y Métodos
Se realizó un estudio de corte transversal con selección en un muestreo por conveniencia entre estudiantes de Medicina de la Facultad de Ciencias Médicas de la Universidad Central del Ecuador. Esta escuela se encuentra ubicada en Quito (a 2700 metros sobre el nivel del mar) y tiene un total de 3 057 estudiantes, por lo que es una de las más grandes de la región Sierra del Ecuador.
Para este estudio se les solicitó a los participantes, quienes debían ser asintomáticos (sin faringoamigdalitis, ni hipertrofia amigdalina), cepillar sus dientes, evitando el uso de antisépticos, para tomar dos muestras mediante hisopado orofaríngeo de las amígdalas y los pilares amigdalinos. El primer hisopado se sometió a la prueba antigénica StrepA (Hexagon 58062 Human ®, Wiesbaden) y el segundo se cultivó en agar base sangre suplementado con sangre de cordero al 5% (Medibac ®, Quito). El medio de cultivo inoculado se incubó en condiciones de microaerofilia a 37°C por 48 horas. En la prueba antigénica los resultados se consideraron positivos cuando la línea de control y la de prueba fueron de color rojo; para el cultivo el criterio de positividad se confirmó cuando se observó el desarrollo de colonias β-hemolíticas que por coloración Gram reflejaron ser cocos grampositivos y catalasas negativas y sensibles a la bacitracina. Se utilizó como control positivo una cepa de S. pyogenes extraída de un paciente sintomático. Las pruebas fueron llevadas a cabo en el Laboratorio de Microbiología de la Facultad de Ciencias Médicas de la Universidad Central del Ecuador. Los participantes dieron su consentimiento informado previo a su inclusión en el estudio.
Resultados
Las muestras fueron recolectadas en noviembre de 2015, fecha que corresponde a la época más lluviosa de Quito. Se detectó que las pruebas de StrepA realizadas en las muestras de 77 estudiantes resultaron todas negativas, además, en tres casos se obtuvo un cultivo positivo de S. pyogenes. Los pacientes con resultados positivos correspondieron a un hombre y dos mujeres de 19 años de edad. La especificidad de la prueba StrepA fue del 100% frente al cultivo, pero la sensibilidad no pudo calcularse debido a la falta de resultados positivos.
Discusión
La colonización asintomática de S. pyogenes en 3.9% de los estudiantes de medicina investigados podría sugerir un riesgo de enfermedad o de fuente de contagio. No hay estudios de prevalencia de portadores asintomáticos en adultos jóvenes, por lo que los resultados encontrados no se pueden comparar con otros reportes. Dado que el muestreo en la presente investigación es no probabilístico, la presencia de esta infección no es extrapolable a la población general, pero da cuenta del potencial en que ciertos microorganismos como la S. pyogenes pueden estar presentes aún en población adulta joven no enferma.
El método de cultivo de exudado faríngeo busca determinar la presencia casi de forma exclusiva de la S. pyogenes, dado que es la principal causa de faringitis bacteriana. Las pruebas rápidas de detección en casos de faringitis poseen buena especificidad, y tal como se corrobora en el presente estudio, no son sensibles, por lo que su resultado negativo debe ser confirmado por cultivo. Es importante señalar que el fundamento de la prueba inmunoenzimática es la detección del antígeno A de Lancefield, por lo que algunas S. pyogenes que no lo expresan pueden dar resultados negativos a pesar de estar presentes en la muestra. Por lo tanto, ni el estado de portador ni la enfermedad pueden ser descartados de manera definitiva por el método inmunocromatográfico; entonces, los resultados de este estudio sugieren que la determinación del estado de portador de S. pyogenes no debería ser realizada con pruebas de detección antigénica, pero sí con pruebas como el cultivo, que confirma su validez entre las pruebas de diagnóstico microbiológico actuales.
Por otro lado, la fisiopatología del estado de portador se explica, en parte, por las infecciones intracelulares en las células epiteliales y en los macrófagos de la orofaringe, en especial por cepas que expresan ciertos tipos de proteínas de unión de alta afinidad a la fibronectina como las SfbI tipo F1, que a su vez se expresan en presencia de condiciones ambientales como el incremento de superóxido, por ejemplo, y que son importantes tanto para su adhesión como para su internalización 12.
Una vez que las bacterias se localizan en el compartimento intracelular, estas pueden permanecer en un estado metabólico inactivo conocido como infección latente que permite la persistencia de la infección en el hospedero; es así como se evita su erradicación tanto por el sistema inmunológico como por la acción de los antimicrobianos, donde, por ejemplo, en el último caso las bacterias permanecen sensibles a los antimicrobianos, pero dicha molécula no puede ejercer su acción dentro de la célula del hospedero 4.
Conclusión
Para la adecuada utilización de los métodos microbiológicos en el diagnóstico de enfermedades infecciosas, es importante contextualizar su resultado con la condición del paciente y reconocer sus limitaciones en sensibilidad, especificidad y otros valores estadísticos de relevancia a fin de evitar el error y de procurar la mejor terapéutica.
Agradecimiento
A los estudiantes del tercer semestre en el período 2015-2016 de la Escuela de Medicina de la Universidad Central del Ecuador por su colaboración en el estudio.
Referencias Bibliográficas
1. Shaikh N, Leonard E, Martin JM. Prevalence of streptococcal pharyngitis and streptococcal carriage in children: a meta-analysis. Pediatrics. 2010;126(3):e557-64. http://doi.org/d54sfq.
2. Efstratiou A, Lamagni T. Epidemiology of Streptococcus pyogenes. In: Ferretti JJ, Stevens DL, Fischetti VA, editors. Streptococcus pyogenes: Basic Biology to Clinical Manifestations. Oklahoma: University of Oklahoma Health Sciences Center; 2016.
3. Murray P, Rosenthal K, Pfaller M. Microbiología Médica. Barcelona: Elsevier; 2014.
4. Matas L, Méndez M, Rodrigo C, Ausina V. Diagnóstico de las faringitis estreptocócicas. Enferm InfeccMicrobiol Clin. 2008;26(Suppl 13);14-18.
5. Rogo T, Schwartz RH, Ascher DP. Comparison of the Inverness Medical Acceava Strep Atest with the Genzyme OSOM and Quidel QuickVue Strep A tests. ClinPediatr (Phila). 2011;50(4):294-296. http://doi.org/b978kj.
6. Plainvert C, Duquesne I, Touak G, Dmytruk N, Poyart C. In vitro evaluation and comparison of 5 rapid antigen detection tests for the diagnosis of beta-hemolytic group A streptococcal pharyngitis. Diagn Microbiol Infect Dis. 2015;83(2):105-111. http://doi.org/f7st6d.
7. Sims-Sanyahumbi A, Colquhoun S, Wyber R, Carapetis JR. Global Disease Burden of Group A Streptococcus. In: Ferretti JJ, Stevens DL, Fischetti VA. Streptococcus pyogenes: Basic Biology to Clinical Manifestations. Oklahoma: University of Oklahoma Health Sciences Center; 2016.
8. Gutiérrez C, Chacón M, Pérez-Ybarra L, Rivero H, Straga S, Luis-León J. Valores referenciales de antiestreptolisina O y portadores asintomáticos de estreptococos β-hemolíticos en adolescentes y adultos del Municipio Francisco Linares Alcántara, Venezuela. Rev Chilena Infectol. 2015;32(6):689-94. http://doi.org/f7st6d.
9. Roberts AL, Connolly KL, Kirse DJ, Evans AK, Poehling KA, Peters TR, et al. Detection of group A Streptococcus in tonsils from pediatric patients reveals high rate of asymptomatic streptococcal carriage. BMC Pediatr. 2012;12:3. http://doi.org/fzgpnm.
10. Walker MJ, Barnett TC, McArthur JD, Cole JN, Guillen CM, Henningham A, et al. Disease Manifestations and Pathogenic Mechanisms of Group A Streptococcus. Clin Microbiol Rev. 2014;27(2):264-301. http://doi.org/f5x97b.
11. Das B, Ray R, Saha AK, Das A, Chatterjee K, Ghosh D. Isolation of Pathogenic Micro-organisms from Throat Swab and Sputum Samples for Identification of Laboratory Acquired Infections (LAI) of The Working Clinical Laboratory Staffs of Hooghly and Burdwan Districts, West Bengal, India: A Comparative Analysis. PARIPEX – Indian Journal of Research. 2016;5(5):105-10.
12. Jadoun J, Ozeri V, Burstein E, Skutelsky E, Hanski E, Sela S. Protein F1 is required for efficient entry of Streptococcus pyogenes into epithelial cells. J Infect Dis. 1998;178(1):147-58. http://doi.org/cbjj.
1Vasco G, Luna C. Detección de la colonización asintomática en orofaringe por Streptococcus pyogenes mediante dos métodos diagnósticos. Rev. Fac. Med. 2017;65(4):633-5. Spanish. doi: http://dx.doi.org/10.15446/revfacmed.v65n4.59741.
2Vasco G, Luna C. [Detection of the asymptomatic oropharynx Streptococcus pyogenes carriage by using two diagnostic methods]. Rev. Fac. Med. 2017;65(4): 633-5. Spanish. doi: http://dx.doi.org/10.15446/revfacmed.v65n4.59741.
Financiamiento. EL presente estudio recibió apoyo como actividad de Vinculación con la Comunidad Cátedra de Microbiología de la Facultad de Ciencias Médicas de la Universidad Central del Ecuador 2015-2016.





